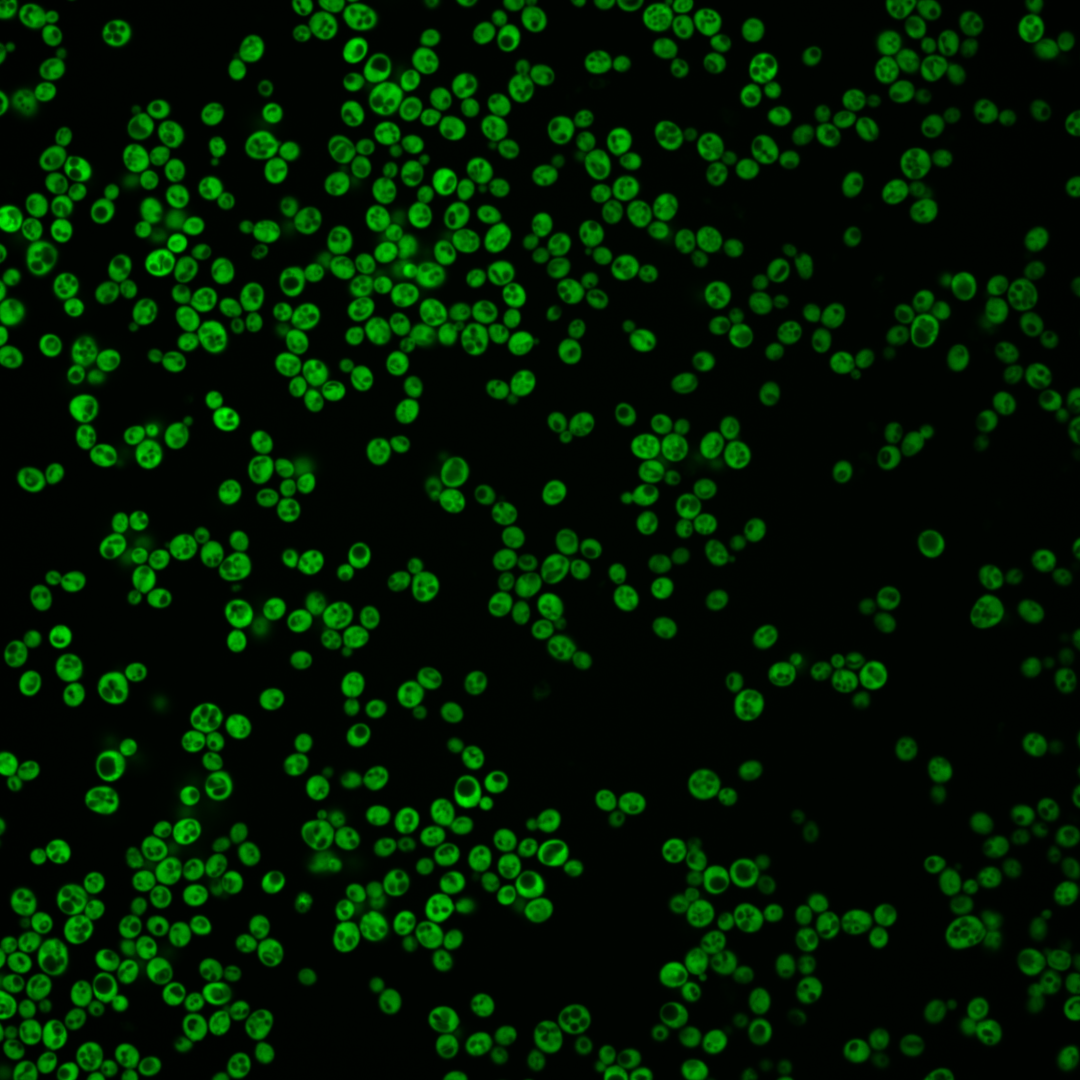
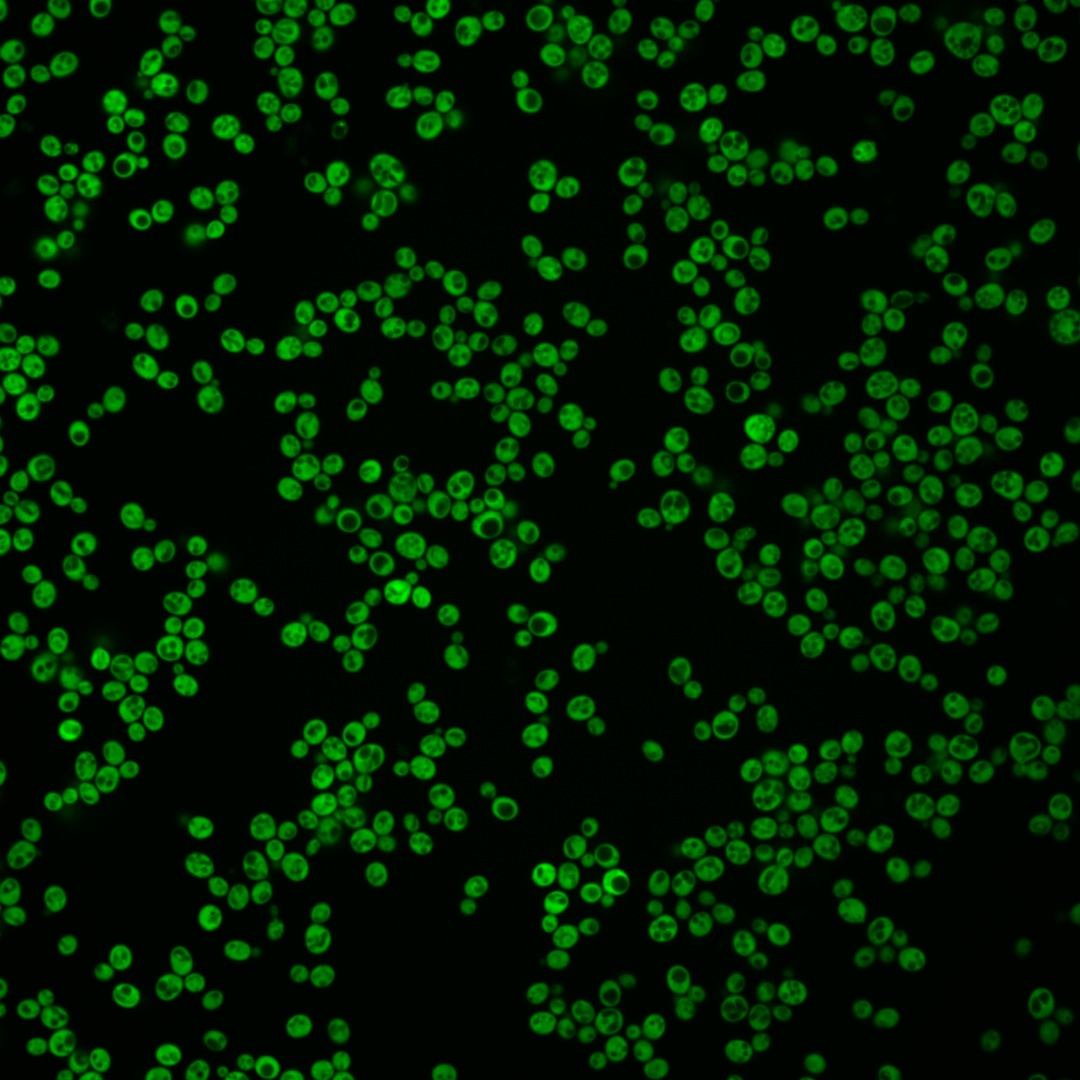

| Standard name | |
|---|---|
| Human Ortholog | |
| Description | Aspartic beta semi-aldehyde dehydrogenase; catalyzes the second step in the common pathway for methionine and threonine biosynthesis; expression regulated by Gcn4p and the general control of amino acid synthesis |
Micrographs




















































































Sub-cellular Localization
Yeast GFP Assignment
Protein Abundance
Localization Change
External localization resources
| ensLOC | DeepLoc | |||||||||||||||||||||||
|---|---|---|---|---|---|---|---|---|---|---|---|---|---|---|---|---|---|---|---|---|---|---|---|---|
| Localization | WT1 | WT2 | WT3 | RAP60 | RAP140 | RAP220 | RAP300 | RAP380 | RAP460 | RAP540 | RAP620 | RAP700 | HU80 | HU120 | HU160 | rpd3Δ_1 | rpd3Δ_2 | rpd3Δ_3 | WT1 | WT2 | WT3 | AF100 | AF140 | AF180 |
| Cortical Patches | 0 | 0 | 0 | 0 | 0 | 0 | 1 | 2 | 4 | 4 | 4 | 8 | 0 | 0 | 0 | 0 | 0 | 0 | 0 | 0 | 0 | 0 | 0 | 0 |
| Bud | 2 | 1 | 1 | 0 | 0 | 0 | 1 | 5 | 1 | 1 | 3 | 4 | 0 | 0 | 1 | 0 | 0 | 0 | 0 | 0 | 0 | 0 | 0 | 3 |
| Bud Neck | 0 | 0 | 0 | 0 | 0 | 0 | 0 | 0 | 0 | 0 | 0 | 0 | 0 | 0 | 0 | 0 | 0 | 0 | 0 | 0 | 0 | 0 | 0 | 0 |
| Bud Site | 0 | 0 | 0 | 0 | 0 | 0 | 0 | 0 | 0 | 0 | 0 | 0 | 0 | 0 | 0 | 0 | 0 | 0 | – | – | – | – | – | – |
| Cell Periphery | 1 | 3 | 5 | 1 | 4 | 10 | 16 | 18 | 10 | 27 | 14 | 30 | 3 | 4 | 8 | 18 | 6 | 5 | 0 | 0 | 0 | 0 | 0 | 0 |
| Cytoplasm | 222 | 165 | 147 | 165 | 257 | 196 | 242 | 299 | 211 | 296 | 192 | 240 | 243 | 337 | 332 | 556 | 371 | 458 | 199 | 157 | 133 | 165 | 296 | 351 |
| Endoplasmic Reticulum | 1 | 0 | 1 | 2 | 4 | 3 | 19 | 32 | 19 | 27 | 7 | 23 | 0 | 0 | 2 | 23 | 22 | 14 | 0 | 1 | 0 | 0 | 1 | 6 |
| Endosome | 0 | 0 | 0 | 0 | 0 | 0 | 0 | 0 | 0 | 0 | 0 | 0 | 0 | 0 | 0 | 0 | 0 | 1 | 0 | 0 | 0 | 0 | 0 | 0 |
| Golgi | 0 | 0 | 0 | 0 | 0 | 0 | 0 | 0 | 0 | 3 | 0 | 0 | 0 | 0 | 0 | 0 | 1 | 2 | 0 | 0 | 0 | 0 | 0 | 0 |
| Mitochondria | 0 | 0 | 0 | 0 | 0 | 0 | 0 | 0 | 1 | 2 | 1 | 1 | 0 | 0 | 0 | 0 | 0 | 1 | 0 | 0 | 0 | 0 | 0 | 0 |
| Nucleus | 0 | 0 | 0 | 0 | 0 | 0 | 2 | 0 | 0 | 0 | 0 | 0 | 0 | 0 | 0 | 0 | 0 | 1 | 0 | 0 | 1 | 0 | 0 | 0 |
| Nuclear Periphery | 0 | 0 | 0 | 0 | 0 | 0 | 0 | 0 | 0 | 0 | 0 | 0 | 0 | 0 | 0 | 0 | 0 | 0 | 0 | 0 | 0 | 0 | 0 | 0 |
| Nucleolus | 0 | 0 | 0 | 0 | 0 | 0 | 0 | 0 | 0 | 0 | 1 | 0 | 0 | 0 | 0 | 1 | 0 | 4 | 0 | 0 | 0 | 0 | 0 | 0 |
| Peroxisomes | 0 | 0 | 0 | 0 | 0 | 0 | 0 | 0 | 0 | 0 | 0 | 0 | 0 | 0 | 0 | 0 | 0 | 0 | 0 | 0 | 0 | 0 | 0 | 0 |
| SpindlePole | 0 | 0 | 0 | 0 | 0 | 0 | 0 | 0 | 0 | 0 | 0 | 0 | 0 | 0 | 0 | 0 | 0 | 0 | 0 | 0 | 0 | 0 | 0 | 0 |
| Vac/Vac Membrane | 0 | 0 | 0 | 0 | 0 | 0 | 0 | 2 | 3 | 7 | 4 | 10 | 0 | 0 | 0 | 0 | 3 | 4 | 0 | 0 | 0 | 0 | 2 | 2 |
| Unique Cell Count | 223 | 168 | 149 | 167 | 262 | 202 | 268 | 343 | 242 | 348 | 211 | 294 | 243 | 337 | 333 | 563 | 374 | 470 | 210 | 163 | 138 | 169 | 309 | 371 |
| Labelled Cell Count | 226 | 169 | 154 | 168 | 265 | 209 | 281 | 358 | 249 | 367 | 226 | 316 | 246 | 341 | 343 | 598 | 403 | 490 | 210 | 163 | 138 | 169 | 309 | 371 |
Yeast GFP Assignment
Protein Abundance
| Screen | WT1 | WT2 | WT3 | RAP60 | RAP140 | RAP220 | RAP300 | RAP380 | RAP460 | RAP540 | RAP620 | RAP700 | HU80 | HU120 | HU160 | rpd3Δ_1 | rpd3Δ_2 | rpd3Δ_3 | AF100 | AF140 | AF180 |
|---|---|---|---|---|---|---|---|---|---|---|---|---|---|---|---|---|---|---|---|---|---|
| Mean Cell GFP Intensity (1e-4) | 93.4 | 139.4 | 99.0 | 96.9 | 87.2 | 70.5 | 55.5 | 54.2 | 47.7 | 43.5 | 40.1 | 41.8 | 124.4 | 109.3 | 107.8 | 161.0 | 185.0 | 181.7 | 108.2 | 104.6 | 103.5 |
| Std Deviation (1e-4) | 18.0 | 25.4 | 23.8 | 22.0 | 19.3 | 17.1 | 14.5 | 13.9 | 13.9 | 11.7 | 11.8 | 12.7 | 27.1 | 25.6 | 26.9 | 35.1 | 45.0 | 54.0 | 26.4 | 28.5 | 24.8 |
| Intensity Change (Log2) | – | – | – | -0.03 | -0.18 | -0.49 | -0.84 | -0.87 | -1.05 | -1.19 | -1.3 | -1.24 | 0.33 | 0.14 | 0.12 | 0.7 | 0.9 | 0.88 | 0.13 | 0.08 | 0.06 |
Localization Change
| Localization | RAP60 | RAP140 | RAP220 | RAP300 | RAP380 | RAP460 | RAP540 | RAP620 | RAP700 | HU80 | HU120 | HU160 | rpd3Δ_1 | rpd3Δ_2 | rpd3Δ_3 |
|---|---|---|---|---|---|---|---|---|---|---|---|---|---|---|---|
| Cortical Patches | 0 | 0 | 0 | 0 | 0 | 0 | 0 | 0 | 0 | 0 | 0 | 0 | 0 | 0 | 0 |
| Bud | 0 | 0 | 0 | 0 | 0 | 0 | 0 | 0 | 0 | 0 | 0 | 0 | 0 | 0 | 0 |
| Bud Neck | 0 | 0 | 0 | 0 | 0 | 0 | 0 | 0 | 0 | 0 | 0 | 0 | 0 | 0 | 0 |
| Bud Site | 0 | 0 | 0 | 0 | 0 | 0 | 0 | 0 | 0 | 0 | 0 | 0 | 0 | 0 | 0 |
| Cell Periphery | 0 | 0 | 0.7 | 1.2 | 0.9 | 0.4 | 1.8 | 1.4 | 2.5 | 0 | 0 | 0 | 0 | 0 | 0 |
| Cytoplasm | 0.1 | -0.4 | -1.0 | -3.3 | -4.0 | -4.0 | -4.5 | -3.1 | -5.1 | 1.8 | 2.1 | 1.3 | 0.1 | 0.6 | -0.9 |
| Endoplasmic Reticulum | 0 | 0 | 0 | 2.9 | 3.5 | 3.1 | 3.1 | 0 | 3.1 | 0 | 0 | 0 | 2.1 | 2.6 | 0 |
| Endosome | 0 | 0 | 0 | 0 | 0 | 0 | 0 | 0 | 0 | 0 | 0 | 0 | 0 | 0 | 0 |
| Golgi | 0 | 0 | 0 | 0 | 0 | 0 | 0 | 0 | 0 | 0 | 0 | 0 | 0 | 0 | 0 |
| Mitochondria | 0 | 0 | 0 | 0 | 0 | 0 | 0 | 0 | 0 | 0 | 0 | 0 | 0 | 0 | 0 |
| Nucleus | 0 | 0 | 0 | 0 | 0 | 0 | 0 | 0 | 0 | 0 | 0 | 0 | 0 | 0 | 0 |
| Nuclear Periphery | 0 | 0 | 0 | 0 | 0 | 0 | 0 | 0 | 0 | 0 | 0 | 0 | 0 | 0 | 0 |
| Nucleolus | 0 | 0 | 0 | 0 | 0 | 0 | 0 | 0 | 0 | 0 | 0 | 0 | 0 | 0 | 0 |
| Peroxisomes | 0 | 0 | 0 | 0 | 0 | 0 | 0 | 0 | 0 | 0 | 0 | 0 | 0 | 0 | 0 |
| SpindlePole | 0 | 0 | 0 | 0 | 0 | 0 | 0 | 0 | 0 | 0 | 0 | 0 | 0 | 0 | 0 |
| Vacuole | 0 | 0 | 0 | 0 | 0 | 0 | 0 | 0 | 0 | 0 | 0 | 0 | 0 | 0 | 0 |
External localization resources
Images






























Protein Concentration and Protein Localization Data
| R1 | R2 | R3 | ||||||||||||||||
|---|---|---|---|---|---|---|---|---|---|---|---|---|---|---|---|---|---|---|
| G1 Pre-START | G1 Post-START | S/G2 | Metaphase | Anaphase | Telophase | G1 Pre-START | G1 Post-START | S/G2 | Metaphase | Anaphase | Telophase | G1 Pre-START | G1 Post-START | S/G2 | Metaphase | Anaphase | Telophase | |
| Concentration | – | – | – | – | – | – | – | – | – | – | – | – | – | – | – | – | – | – |
| Actin | 0.0007 | 0.0001 | 0.0068 | 0.0001 | 0.0334 | 0.0008 | 0.0025 | 0 | 0.0013 | 0.0002 | 0.0002 | 0.0001 | 0.0535 | 0.0001 | 0.0001 | 0 | 0.0065 | 0.0002 |
| Bud | 0.0005 | 0.0001 | 0.0003 | 0.0001 | 0.001 | 0.0005 | 0.0008 | 0 | 0.0006 | 0.0004 | 0.0005 | 0 | 0.0014 | 0 | 0 | 0 | 0.0054 | 0 |
| Bud Neck | 0.0003 | 0.0002 | 0.0004 | 0.0001 | 0.0008 | 0.0006 | 0.0002 | 0.0001 | 0.0002 | 0.0002 | 0.0004 | 0.0004 | 0.0001 | 0.0001 | 0.0001 | 0.0001 | 0.0002 | 0.0003 |
| Bud Periphery | 0.0003 | 0 | 0.0003 | 0 | 0.0008 | 0.0001 | 0.0004 | 0 | 0.0005 | 0.0002 | 0.0003 | 0 | 0.0012 | 0 | 0 | 0 | 0.0029 | 0 |
| Bud Site | 0.0008 | 0.0001 | 0.0004 | 0 | 0.0012 | 0 | 0.0028 | 0 | 0.0004 | 0.0002 | 0.0001 | 0 | 0.0007 | 0 | 0 | 0 | 0.0019 | 0 |
| Cell Periphery | 0.0007 | 0.0006 | 0.0008 | 0.0002 | 0.0013 | 0.0041 | 0.0007 | 0.0002 | 0.0004 | 0.0006 | 0.0004 | 0 | 0.0005 | 0 | 0 | 0 | 0.0018 | 0 |
| Cytoplasm | 0.9252 | 0.9914 | 0.9355 | 0.9755 | 0.8114 | 0.9728 | 0.953 | 0.9971 | 0.9798 | 0.8874 | 0.9466 | 0.9957 | 0.4456 | 0.998 | 0.9916 | 0.9971 | 0.0114 | 0.9959 |
| Cytoplasmic Foci | 0.0122 | 0.0001 | 0.0063 | 0.0011 | 0.011 | 0.0011 | 0.0094 | 0.0002 | 0.0017 | 0.0288 | 0.009 | 0.0003 | 0.0014 | 0.0001 | 0.0001 | 0.0001 | 0.0041 | 0.0003 |
| Eisosomes | 0.0002 | 0.0001 | 0.0006 | 0 | 0.0004 | 0 | 0.0003 | 0 | 0.0001 | 0.0006 | 0 | 0 | 0.0011 | 0 | 0 | 0 | 0.0005 | 0 |
| Endoplasmic Reticulum | 0.0008 | 0.0002 | 0.0037 | 0.0002 | 0.0011 | 0.0006 | 0.0004 | 0.0001 | 0.0004 | 0.0002 | 0.0003 | 0.0001 | 0.003 | 0 | 0 | 0 | 0.0002 | 0.0001 |
| Endosome | 0.0018 | 0 | 0.0045 | 0.0001 | 0.0051 | 0.0005 | 0.0018 | 0 | 0.0011 | 0.0004 | 0.0004 | 0.0001 | 0.0027 | 0 | 0.0001 | 0 | 0.0054 | 0 |
| Golgi | 0.0006 | 0 | 0.0018 | 0 | 0.007 | 0.0001 | 0.0005 | 0 | 0.0012 | 0.0001 | 0 | 0 | 0.0009 | 0 | 0 | 0 | 0.0021 | 0 |
| Lipid Particles | 0.0048 | 0.0001 | 0.0041 | 0.0001 | 0.008 | 0.0007 | 0.0008 | 0.0002 | 0.0002 | 0.0052 | 0.0005 | 0 | 0.0004 | 0 | 0 | 0 | 0.0016 | 0 |
| Mitochondria | 0.0062 | 0.0005 | 0.0069 | 0.0005 | 0.0132 | 0.0002 | 0.0022 | 0 | 0.0067 | 0.0108 | 0.0029 | 0 | 0.0508 | 0 | 0 | 0 | 0.8309 | 0.0001 |
| None | 0.0071 | 0.0003 | 0.0049 | 0.0098 | 0.0114 | 0.0005 | 0.0066 | 0.0003 | 0.0008 | 0.023 | 0.02 | 0.0001 | 0.0103 | 0.0001 | 0.0001 | 0 | 0.0037 | 0.0002 |
| Nuclear Periphery | 0.0069 | 0.0011 | 0.0024 | 0.0027 | 0.006 | 0.0025 | 0.002 | 0.0003 | 0.0008 | 0.0008 | 0.0025 | 0.0005 | 0.2554 | 0.0004 | 0.0017 | 0.0003 | 0.0022 | 0.0005 |
| Nucleolus | 0.0112 | 0.0021 | 0.0082 | 0.001 | 0.0379 | 0.0002 | 0.0033 | 0.0001 | 0.0012 | 0.0238 | 0.002 | 0 | 0.0023 | 0 | 0 | 0 | 0.0086 | 0 |
| Nucleus | 0.0107 | 0.0023 | 0.0036 | 0.005 | 0.0311 | 0.0038 | 0.0075 | 0.0008 | 0.0017 | 0.0033 | 0.0082 | 0.002 | 0.1085 | 0.001 | 0.0034 | 0.0022 | 0.0113 | 0.0022 |
| Peroxisomes | 0.0031 | 0 | 0.0021 | 0 | 0.003 | 0 | 0.0004 | 0 | 0.0001 | 0.0013 | 0.0002 | 0 | 0.0008 | 0 | 0 | 0 | 0.0064 | 0 |
| Punctate Nuclear | 0.0012 | 0 | 0.0014 | 0.0003 | 0.0037 | 0.0002 | 0.0015 | 0 | 0.0001 | 0.0011 | 0.0004 | 0 | 0.0316 | 0 | 0 | 0 | 0.0001 | 0.0001 |
| Vacuole | 0.003 | 0.0006 | 0.0024 | 0.0019 | 0.0052 | 0.0091 | 0.002 | 0.0004 | 0.0006 | 0.0062 | 0.0037 | 0.0004 | 0.0022 | 0 | 0.0014 | 0 | 0.0209 | 0 |
| Vacuole Periphery | 0.0018 | 0.0002 | 0.0026 | 0.0012 | 0.0058 | 0.0014 | 0.0008 | 0 | 0.0003 | 0.0053 | 0.0014 | 0.0001 | 0.0256 | 0 | 0.0013 | 0 | 0.0717 | 0 |
Sequencing Data
| R1 | R2 | |||||||||
|---|---|---|---|---|---|---|---|---|---|---|
| G1 Post-START | S/G2 | Metaphase | Anaphase | Telophase | G1 Post-START | S/G2 | Metaphase | Anaphase | Telophase | |
| Gene Expression | 162.2949 | 212.9063 | 261.9763 | 220.6526 | 182.4096 | 250.0871 | 323.3582 | 274.0323 | 297.2855 | 251.1053 |
| Translational Efficiency | 3.0845 | 2.7048 | 2.181 | 2.4444 | 3.0136 | 2.5245 | 2.3955 | 2.5837 | 2.3481 | 2.3665 |
Hit Data
| Dataset | Hit |
|---|---|
| Protein Concentration | – |
| Protein Localization | ✘ |
| Gene Expression | ✘ |
| Translational Efficiency | ✘ |
Endocytosis
| Temp | Actin Patch (Sac6-tdTomato) | Cortical Patch (Sla1-GFP) | Late Endosome (Snf7-GFP) | Vacuole (Vph1-GFP) |
|---|---|---|---|---|
| 37℃ | ||||
| RT |
Cell Cycle Omics
CYCLoPs (Hom2-GFP)
| Gene / Allele | Actin Patch (Sac6-tdTomato) | Cortical Patch (Sla1-GFP) | Late Endosome (Snf7-GFP) | Vacuole (Sac6-tdTomato) |
|---|
| Gene | Images |
|---|
| Gene | Images |
|---|
Images are not yet available
Images are not yet available